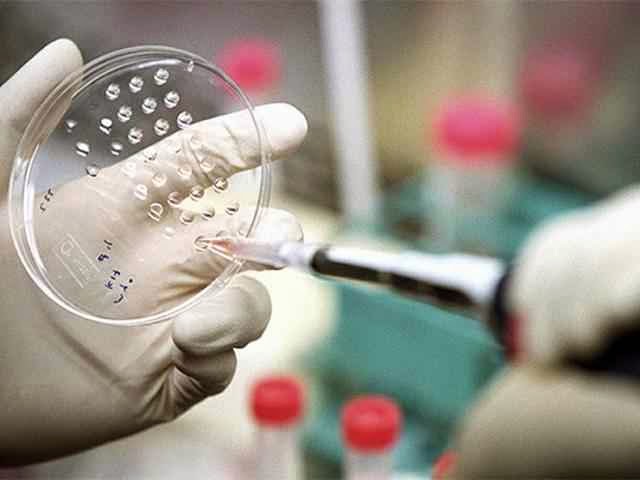

El sueño de destruir el cáncer
con células del sistema inmune programadas para atacar a los tumores ha
dado un paso de gigante. La gran esperanza se llama “célula madre T de
memoria” (TSCM), y es un tipo radicalmente nuevo de glóbulo
blanco del sistema inmune que reúne las dos propiedades ideales: por un
lado son células madre, y por tanto tienen la capacidad de
autorrenovarse de manera indefinida; y por otro tienen memoria
inmunológica, por lo que conservan, también indefinidamente, su
capacidad para actuar contra un agente infeccioso concreto o un tumor
específico. Científicos de Milán han demostrado que pueden subsistir al
menos 12 años en el cuerpo de 14 pacientes.
El pequeño ensayo clínico no había sido planeado para este fin –las células TSCM
ni siquiera habían sido descubiertas hace 12 años, cuando la prueba
comenzó—, sino para probar la seguridad de una técnica de terapia génica
contra un tipo de inmunodeficiencia hereditaria (SCID, o enfermedad de
los niños burbuja). Pero Luca Biasco, Serena Scala, Alessandro Aiuti y
sus colegas del Instituto Científico San Raffaele, en Milán, han
encontrado una forma brillante de reciclar el ensayo para obtener unos datos esenciales en la lucha contra el cáncer.
Los resultados se presentan en Science Translational Medicine, la publicación que la revista Science
reserva para las investigaciones que tienen una evidente o inmediata
aplicación a la práctica clínica. El subíndice del término TSCM significa stem cell memory,
o células madre de memoria. La T viene de mucho antes: los linfocitos, o
glóbulos blancos de la sangre, son las células encargadas de la
respuesta inmune, y se dividen en linfocitos B (que producen los
anticuerpos que andan sueltos por la sangre) y linfocitos T,
que montan un tipo menos popular pero más importante de defensa: la
inmunidad celular, por la que ciertas células especializadas se tragan,
literalmente, a los agentes infecciosos y a otras cosas que consideren
raras, incluidas en ocasiones las células tumorales.
“Las terapias basadas en células T”, explica Luca Biasco,
primer autor del trabajo, “representan una de las estrategias
terapéuticas más avanzadas y prometedoras para el tratamiento del
cáncer; esta tecnología está basada en la modificación genética de las
células T para redirigir su actividad contra las células tumorales; un
tipo de célula T como las TSCM, que son capaces de mantener
su capacidad de autorrenovación y de diferenciación por muchos años,
pueden aportar un reservorio de células T capaz de patrullar
por el sistema inmune y activarse eficazmente en caso de recidiva del
tumor, para mantener una respuesta inmune secundaria eficiente”.
Nadie tenía ni idea sobre la mera existencia de las células TSCM
hasta 2011. Pero su descubrimiento, especialmente después de este
trabajo, las hacen muy relevantes para diseñar nuevas estrategias útiles
para la medicina. “Aportamos evidencias de que la ingeniería genética
de células T puede ser segura incluso a largo plazo”, explica Biasco. “Y
además demostramos por primera vez de que las células TSCM
con los genes corregidos en el laboratorio pueden implantarse
activamente en la médula ósea de los seres humanos; esto abre la
posibilidad de explotar las células TSCM modificadas genéticamente para las terapias basadas en el sistema inmune”.
Los pacientes empezaron el ensayo clínico en un estudio pionero de terapia génica contra una inmunodeficiencia congénita
dirigido en 1995 por Claudio Bordignon, también en el San Raffaele de
Milá. Las células T de estos pacientes fueron extraídas, y su
deficiencia fue corregida en el laboratorio infectándolas con
un gen correcto introducido dentro del ADN de un virus capaz de
integrarse en el genoma de las células humanas (un retrovirus, de la
familia del virus del sida).
Estos retrovirus se integran en el genoma humano más o menos al azar,
y por tanto cada célula humana que ha recibido el virus tiene una firma molecular
característica, formada por los extremos del ADN del virus unidos a su
contexto de ADN humano. Este es el marcador que Biasco y sus colegas han
aprovechado para identificar y analizar a las células T que siguen
circulando por la sangre de los pacientes 12 años después.
Fuente: El País
No hay comentarios:
Publicar un comentario